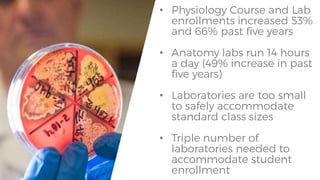
•
•
•
•

The document proposes building a new science building at Dixie State University (DSU) based on several factors:
DSU has experienced the second highest growth rate in student headcount among Utah universities. A new science building is proposed in DSU's approved campus master plan to support additional students in science programs. The building site is located near existing and planned pedestrian paths and parking areas according to the master plan.
A table shows projected population and workforce growth in southern Utah counties including Washington County where DSU is located. The region will need additional healthcare workers and the science building could help increase degrees in fields like nursing.
In a table ranking capital development project proposals across Utah universities, DSU's new science building scores